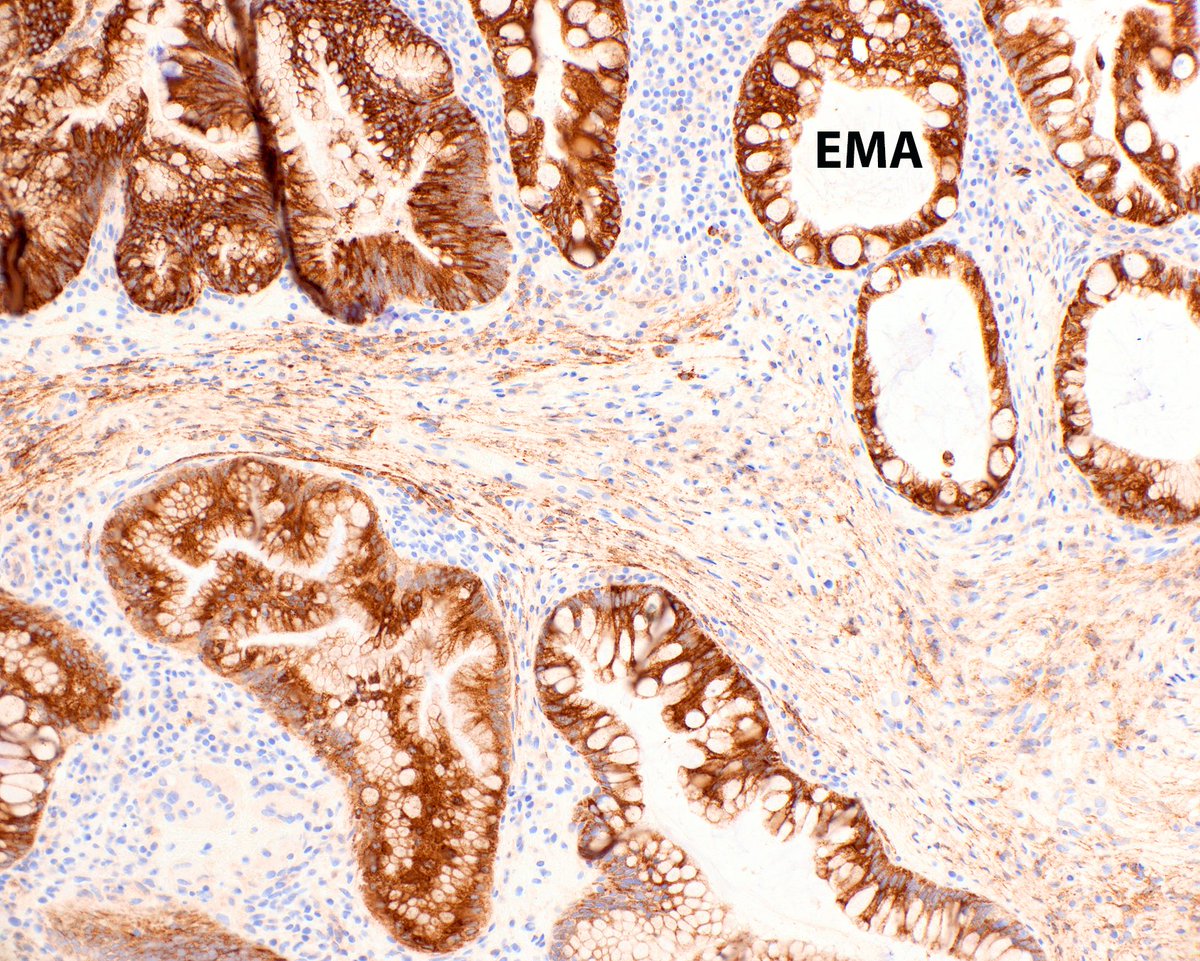
This sessile serrated adenoma (polyp, lesion) has dysplasia with loss of MLH1 (the case about half the time) and an associated benign perineurial proliferation.  What more can a gal ask?
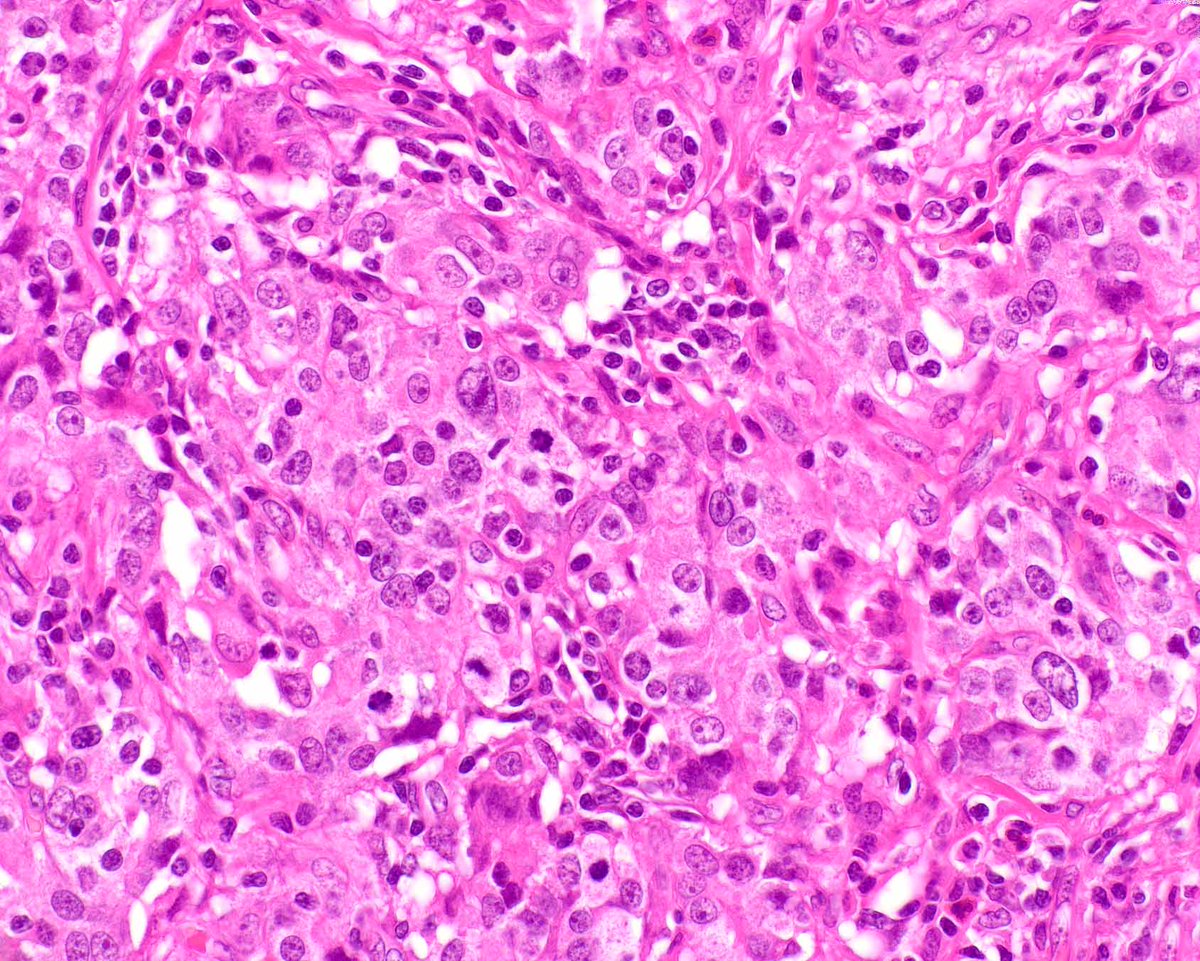
Another spectacular EBV-associated gastric carcinoma (gastric carcinoma with lymphoid stroma).  This example has overt gland formation and more sheet-like areas.

Dr.hou
@drhou_pathology
I am Dr hou attending in Pathology
ID: 1043832967
29-12-2012 04:32:44
1,1K Tweet
565 Followers
283 Following














Adult male with epigastric pain. Olaleke Folaranmi Celina Stayerman MD Lorand Kis Ankur Sangoi Tim Bracey Kalyani Bambal Adam L. Booth, MD